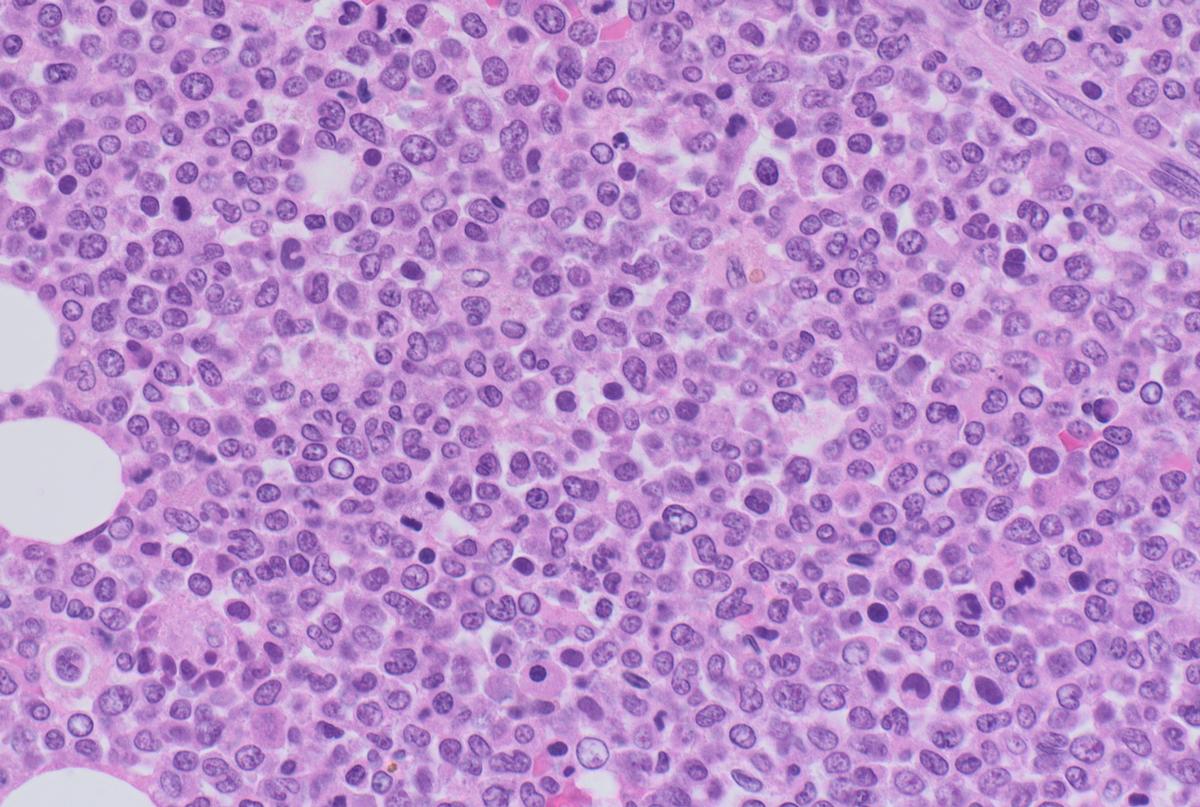
Bone marrow tissue under a microscope

Dr. Dorothee Bienzle Honoured with a Lifetime Achievement Award

Dr. Dorothee Bienzle, recently retired professor emerita in OVC’s Department of Pathobiology, was honoured by the American Society of Veterinary Clinical Pathology (ASVCP) with the 2024 Lifetime Achievement Award for her extensive work in veterinary clinical pathology.
This award recognizes members of the ASVCP who have made a strong contribution over many years to the profession of veterinary clinical pathology – a field focused on the investigation and diagnosis of disease in animals.
Bienzle has advanced training in the fields of veterinary pathology and human immunology. She taught in OVC’s veterinary medicine and graduate programs in addition to leading a robust research program.
“Dorothee has been a pillar in the world of veterinary clinical pathology for decades, both here at OVC and within the broader profession,” says Dr. Brandon Lillie, Chair, Department of Pathobiology. “She has shown unwavering care, engagement and mentorship to clinical pathology trainees, graduate and undergraduate students and early career faculty across multiple disciplines. To say Dorothee has left big shoes to fill would be an understatement — she is irreplaceable. Instead, she leaves behind a profound and enduring legacy on the clinical pathology profession and the Department of Pathobiology.”
Bienzle has been recognized both locally and nationally for her research and teaching excellence. She has held the Canada Research Chair in Veterinary Pathology and a Medical Research Council of Canada’s Doctoral Fellowship in addition to numerous teaching and mentorship awards throughout her career. She was previously elected as a member of the Canadian Academy of Health Sciences and has mentored junior faculty in several departments at OVC, many of whom are now established and successful mid-career researchers.
One of her research interests is equine asthma. Many older horses develop ‘heaves’, the equine-equivalent of human asthma, from regular exposure to dusty hay, straw and mold spores. It is an uncomfortable condition for horses, which is why Bienzle aims to identify how to diagnose heaves earlier and explore how this disease develops in the first place.
Another part of her research program aims to better understand feline immunodeficiency virus (FIV) — the feline counterpart of human immunodeficiency virus. Every cat responds differently to the virus, leading to unpredictable development of immunodeficiency. Bienzle aims to better understand why cats respond variably to FIV.
In the photo: Bone marrow tissue from a dog with acute myeloid leukemia. This dog had been severely anemic for several weeks. A bone marrow biopsy showed an extensive infiltration by poorly differentiated leukemia cells.
The last major arm of her clinical research program investigates lymphoma and leukemia, which are both cancers affecting blood cells. Her work aims to develop better tests to diagnose and characterize the many different types of these blood cancers affecting dogs and cats.
Bienzle also has a special interest in comparative health research, which is the study of diseases common to animals and humans. She has collaborated with veterinarians and physicians worldwide to standardize how specimens for cancers in animals are obtained, tested and interpreted.
She has translated lab research into tools clinicians can use to diagnose animal disease and her work has led to fundamental discoveries that advance both animal and human health.
She has given back to the veterinary profession and the scientific community through her work on various committees and initiatives, including both the American Society for Veterinary Clinical Pathology and the American College of Veterinary Pathologists (ACVP), as well as serving as the President of the American College of Veterinary Pathologists.
“This award is a deeply appreciated, tremendous recognition from my peers across the world,” Bienzle says. “I have always worked in a team, and wholeheartedly acknowledge the amazing contributions from trainees, staff and colleagues throughout my career.”
The OVC community extends our congratulations to Dr. Dorothee Bienzle!
